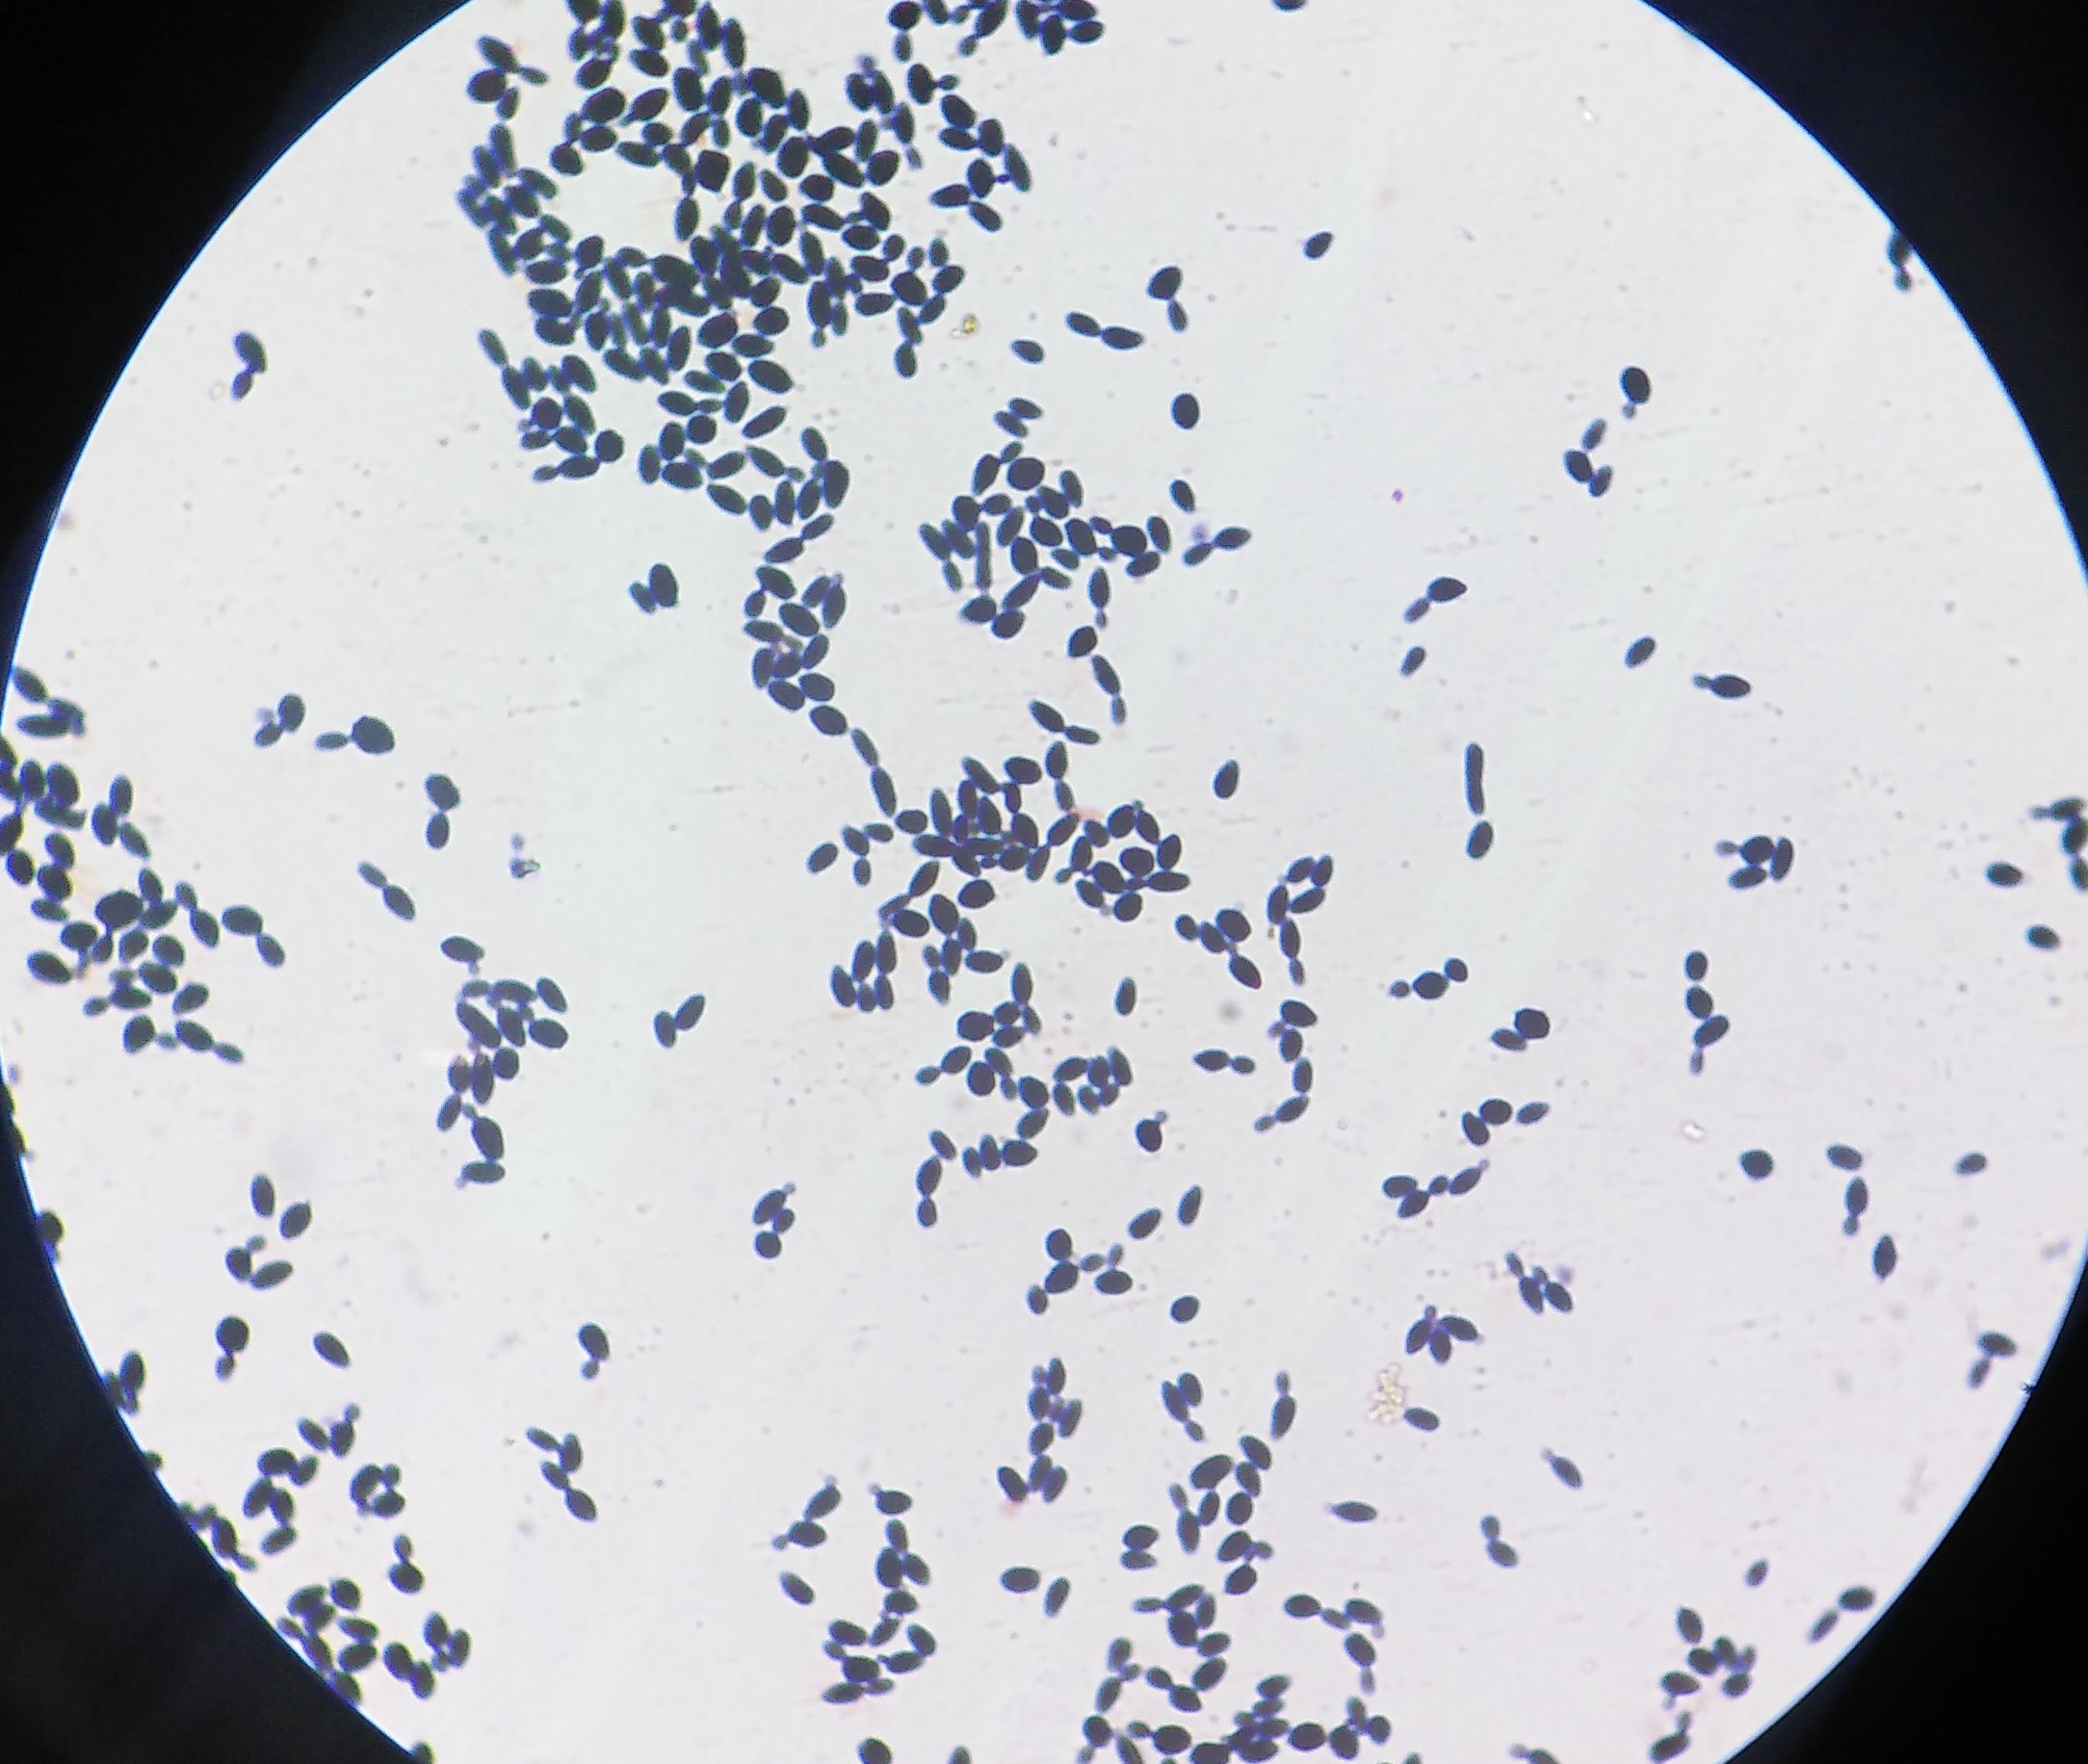
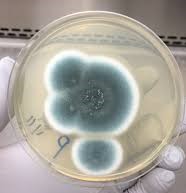

Lab

ABOUT AMDRC LAB
Advanced Mycology Diagnostic & Research Lab
The UP's first advanced mycology centre has been approved by ICMR in 2021, to enhance the diagnostic procedure of mycology. The centre aims to serve the patient that loses their life due to late detection of fungal infections.
Our center is mainly focused on early and accurate diagnosis of all forms of fungal infections. It provides conventional as well as molecular techniques to diagnose life threatening infections like aspergillosis, candidiasis, mucormycosis, histoplasmosis and pneumocystis pneumonia. We planned this set up to overcome the neglect and to make visible change in morbidity and mortality due to fungal infections and awareness building.